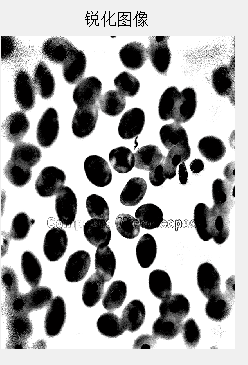
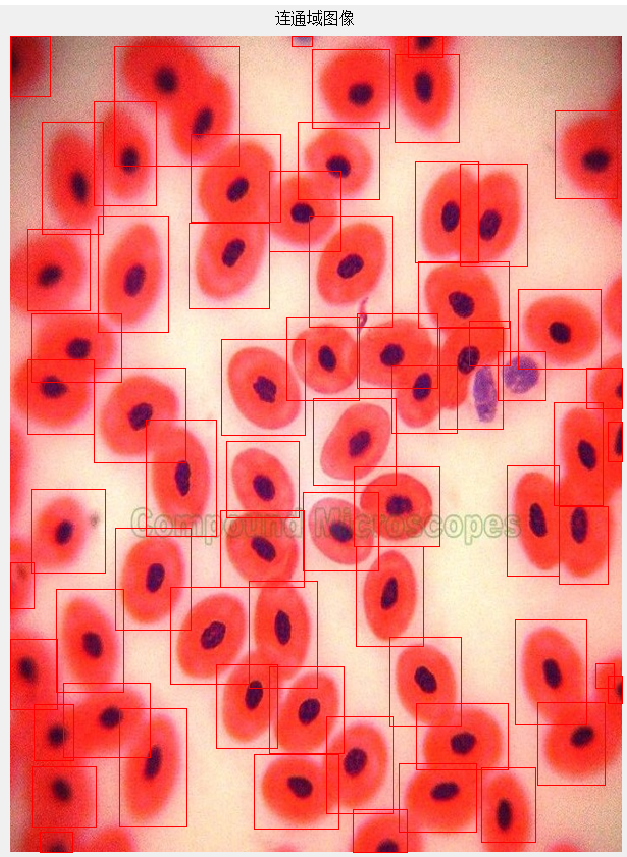

基于显微镜下细胞图像分割与计数系统设计毕业论文
2020-02-17 23:05:47
摘 要
显微镜下血液细胞图像的分割与计数是现代医学中很重要的组成部分,为了了解患者的健康状况,医生需要提取患者的血液细胞进行医学检查,这部分检测对于患者的医治有很大的意义,医生通常会把血液细胞图像的诊断分析结果作为诊断患者健康状况的指标[1]。
本文基于Matlab设计显微镜下血液细胞图像分割与计数系统,可以分割血液细胞图像中的多个细胞,并对分割后的细胞计数,能处理多个细胞部分重叠以及细胞位于图像边缘的特殊情况。设计步骤主要包含细胞图像预处理、图像预分割、重叠细胞分割、细胞计数等。准确的分割细胞,对于后续细胞分析很重要。分割的质量将会影响细胞图像的分析、识别与研究的正确性。因此,在医学领域,细胞分割和统计功能很重要,细胞自动识别和分析的关键困难就在于此。通过比较各种图像分割算法的优劣性,最终采用了阈值二值化分割方法分割细胞,运用分水岭算法对粘连细胞进行分开处理,每个细胞都相当于一个连通域,经过计算连通域的数目,即可得到图像中细胞的个数。
本设计能通过对显微镜下血液细胞的彩色图像进行处理和分析,统计出图像中的细胞个数,对于重叠的细胞能进行分割,位于图像边缘的细胞也能识别出来,准确率达到95%以上,与手工统计的方法比较,该方法对工作效率有显著的增加。
关键词:细胞分割,细胞计数,分水岭算法,MATLAB
Abstract
The segmentation and counting of blood cell images under the microscope is an important part of modern medicine. In order to understand the health of patients, doctors need to extract the blood cells of patients for medical examination. This part of the test has great significance for the treatment of patients. Doctors often use diagnostic analysis of blood cell images as an indicator of a patient's health.
Based on Matlab's design of blood cell image segmentation and counting system under the microscope, this paper can segment and process multiple cells in blood cell images, and can deal with the special cases where multiple cells overlap and cells are located at the edge of the image. The design steps mainly include cell image preprocessing, image pre-segmentation, overlapping cell segmentation, cell counting, and the like. In order to accurately analyze cell images, the most important thing is to accurately segment blood cell images. The quality of the segmentation will affect the correctness of the analysis, identification and research of the cell image. Therefore, cell division and counting are very important for medicine, and the key difficulty in automatic cell identification and analysis is this. By analyzing the advantages and disadvantages of various image segmentation algorithms, the threshold binarization segmentation method is used to segment the cells, and the watershed algorithm is used to segment the overlapping cells. Each cell is equivalent to a connected domain, and the number of connected domains is calculated. The number of cells in the image can be obtained.
This design can process and analyze the color image of blood cells under the microscope, and count the number of cells in the image. For overlapping cells, the cells at the edge of the image can be identified, and the accuracy rate is over 95%. Compared with the method of manual statistics, this method greatly improves the work efficiency.
Key Words: Cell segmentation, cell counting, watershed algorithm, MATLAB
目录
第1章 绪论 1
1.1 研究背景及意义 1
1.2 国内外研究现状 2
1.3 本文研究内容 4
第2章 方案论证与设计 5
2.1 基于阈值的分割 5
2.2 基于边缘检测的分割 5
2.3 基于区域的分割 6
2.4 方案选择 6
第3章 显微镜下细胞图像分割与计数系统的设计 7
3.1 图像预处理 7
3.1.1 图像灰度化处理 7
3.1.2 图像高斯模糊处理 8
3.1.3 图像锐化处理 8
3.2 图像预分割 9
3.2.1 全局阈值分割处理 9
3.2.3 图像腐蚀与膨胀处理 10
3.3 重叠细胞分割 11
3.4 细胞计数 12
第4章 系统程序设计 13
4.1 图像二值化程序设计 14
4.1.1 图像灰度化程序实现 14
4.1.2 图像高斯模糊程序实现 14
4.1.3 图像USM锐化程序实现 14
4.1.4 图像二值化程序实现 15
4.2 重叠细胞分割与细胞计数程序设计 16
4.2.1 重叠细胞分割程序实现 16
4.2.2 细胞计数程序实现 16
4.3 系统运行结果分析 17
第5章 总结与展望 20
致 谢 22
参考文献 23
第1章 绪论
1.1 研究背景及意义
21世纪的当今,计算机科学对人类社会的现代化发展起着很重大的作用,相关科技发展迅速,其中图像处理相关技术与人们生活活动不可分离,相关技术受到了各行各业的重视[2]。如今,它已经普遍存在医学,机器人视觉,电子商务等领域。21世纪既是信息时代,也是生物学的时代,有了图像处理的助力,生物医学将会快速进步。细胞是生命体基本的组成单元,因而,对生命体活动的研究离不开对细胞的研究。
现代医学之所以相比于传统医学能有很大的进步,离不开微观观察设备的出现和计算机行业的发展。显微镜的出现让科研人员可以观察到生命体的微观世界,从而了解生命体运行的原理。其中,对细胞的观察很重要,作为生命体的基本单元,细胞的各项参数能反馈给人们很多重要的信息,通过研究细胞各项参数,可以实现对个体生理状况的了解。
以目前的医疗手段,医学工作者陆陆续续发现了许多疾病,主要包括感染性疾病,血液病,遗传病等,很多疾病需要进行血液细胞检查才能发现。作为人体很重要的循环系统,血液在医学常规检查中也很重要,血液的各项参数是否正常关系到人体的健康状况。
在临床医学领域中,人体的血液细胞图像主要通过医学显微镜获取,然后采用人工目视的方式来分析细胞图像,从而诊断人体健康状况,这种方法一直是被广泛采用。然而,这样方式的弊端也很明显,细胞图像常常不清晰,细胞很多,重叠也很严重,工作人员长时间观察会视觉疲劳,导致浪费时间,效率低下,计数与分析准确率较低。这时,图像处理技术的优势就体现出来了。使用图像处理技术,可以很大程度上消除人工带来的弊端,可以高效而精确的分析细胞图像[3]。然而,相关的医学仪器设备售价很高,对仪器操控人员的技术能力有不小的要求,在临床使用中有不小的局限性。得益于图像处理技术的不断壮大,使用更方便,其在生物医学中应用更普及,作用更大。
医护人员进行救治工作时离不开计算机的使用,计算机相当于一对翅膀,让医护人员可以更轻松,快捷的进行病情检测。临床中常用到的图像处理设备主要有心电图,脑电波检测器等,这些高精度的先进医用器材提升了医护人员的工作效率。现在人口日益增多,医疗资源有限,提高医护工作者的工作效率能让更多的患者及时接受治疗,这样可以拯救更多的生命。所以计算机对于临床的应用不可或缺。生产出更高效,快捷的,高精度的医用设备是一件很重要的事。
随着科技的发展进步,如今计算机和医学之间的联系更加密切。然而,到现在为止,在相关方面的技术研究并不集中,无论是通过图像处理设备获得某些病变的结论,还是从用于处理某种医学图像的算法等方面来看。用计算机处理医学细胞时,为了准确地分析细胞图像,关键是正确地分割图像。细胞图像分割的效果是否好会对之后的分析阶段有很大影响,同时该步骤也是难点所在,所以这是很关键的一步。由于这些原因,自上世纪以来,国内外许多学者开始研究它。经过几十年的研究,研究人员发明了很多种分割算法。然而,专家和学者并没有停止相关方面的研究,而是积极致力于寻找更有效和通用的算法。然而,直至今日,还没存在通用的高精度算法。这主要是因为图像中的像素灰度值通常不是连续的,这降低了图像的对比度,会使某些目标区域的边缘和背景难以区分,所以很容易分割错误。每种分割算法都使用图像的某些特定属性进行分割。同一种算法不一定适用于不同的图像,不同的分割算法适用的分割条件不同。
1.2 国内外研究现状
细胞识别与分析系统是医学领域不可或缺的工具,它的功能是对医学细胞图像识别和分析,从图像中把细胞划分开,并且分割开重叠的细胞,对各细胞进行计数和其他参数获取。细胞图像的分割算法存在技术瓶颈,但同时这也是细胞图像处理不可或缺的一部分。
所谓图像分割,指的是通过计算机自动识别出图像当中的需要提取的区域,通过一定的算法规则将其从图像中取出。图像分割的方法有很多,有的根据图像中的颜色分布状况进行的分割,将符合相同颜色的区域按照某种准则分割出来,有的是根据纹理来对图像进行划分的等等。图像分割的原理有很多,按照原理设计出来的算法也多种多样,每年都会出现很多新的分割算法。
图像分割技术自问世开始,就一直吸引众多的国内外科研人员投身入其中,经过几十年的发展,关于图像分割的研究仍然火热,各行各业的发展都与之密不可分。特别在医学方面,医学进入快速的发展时期与计算机的进步是同步的,临床医学离不开计算机的应用。图像处理技术开启了新的医学纪元,现在的医用图像处理器材多达上万种,很多疾病在这些设备的帮助下得到很好的检测和治疗,给患者带来了希望。
到目前为止,国内外学者通过几十年的研究,在图像分割方面提出了很多有效的算法,细胞图像自动分析的应用得以快速发展,然而,还没有可以快速、精准、高效分析全部细胞图像的算法。所以科研工作者根据具体需要,通过分析不同细胞的特点提出了许多种类的分割算法,不同的算法适用条件各异。现如今,细胞图像分割技术大体上划成两种:边缘分割方法,它的原理是根据图像边界的灰度值存在不连续的特点来进行分割的,例如,Hough变换,梯度阈值分割,矢量量化,表面拟合等。另外一种分割方法是区域分割,该方法是根据目标区域的灰度近似度来进行图像分割的。近几十年来,国内外的科研工作者发明了一种基于动态轮廓模型[4]的算法。几何变形模型的水平集方法可以自动改变拓扑结构,这种分割方法特别合适颜色丰富,繁杂的图像分割,已经大量应用在医学中,并得到了很好的成效。
对血液细胞数目进行统计在临床中是一项相当重要的工作,而细胞计数离不开细胞分割,因为细胞图像的细胞很多,而且细胞是随机分布,常常会出现多个细胞发生重叠的现象,如果要使用计算机对细胞自动计数,则必须进行细胞分割操作。通过分析国内外当前的细胞分割算法,会发现很多方法是应用于细胞规则的、清晰的图像的分割,而当图像中存在很多杂质噪声时,或者细胞不规则,背景与细胞边界模糊的情况下,很多分割方法都会产生极大的误差,这对细胞计数会产生很大的影响,而且现在很多细胞分割算法都是处于实验阶段,应用于实际的算法很少,所以研究出一种能高效的,精准的细胞分割方法是一件相当重要的事情,这其中具有很大的商业价值和社会意义。目前很多分割算法主要还是国外研究者提出的,国内在细胞分割这方面的研究和投入相对要少一些,还有很大的发展空间,希望国内能在这方面能引起重视,多投入资金和人才进行研发。
人工目视统计细胞个数是一项耗时低效的工作,倘若能通过计算机自动计数,将会使这项工作变得高效简单[5],现在,得益于图像分割相关算法的发展,国内外研究者在此基础上开发了许多具有细胞计数功能的软硬件系统。这些细胞分割与计数系统主要用于实际操作,对其性能有较高的要求,算法越简单,系统运行速度越快,分割与计数的精度越高,高度自动化,系统越稳定,则使用效果越好,这也是研究者所追求的。
上世纪50年代,WallanceH.Coulter发明了第一台血液细胞计数器,他是利用血液细胞导电性能比较差的原理,将血液细胞放入某种导电的溶液中,如果血细胞通过了专门用来计数的孔洞,就会检测到电流的变化,从而知道有细胞通过,以此来进行计数,可以统计出细胞的个数。虽然设备简陋,但这是最早期的细胞计数装置。现如今,伴随着图像处理技术的诞生以及发展,细胞计数系统由原来的简单的硬件装置逐步变成了软硬件结合的高精度自动计数系统。
骨髓造血功能对人体健康有很关键的作用,血液中网织红细胞的数值可以反馈其功能的好坏程度[6],所以通过统计网织红细胞的数值就能诊断患者的骨髓造血功能。当时,由于技术不够成熟,很多医学研究人员大多使用显微镜的目视检查方法来统计网织红细胞的数目,但是人工目视观察低效且不精确。20世纪初,日本的一家名为Sysmex的企业发布了R-1000网织红细胞分析仪器。从而开始了使用分析仪,而不是目视检查。从实验到临床应用均取得了相当不错的成效。自20世纪末开始,可以进行血液细胞计数的仪器陆续的出现,从此,血液细胞计数仪器的应用进入了一个全新的时代。很多高端仪器制造公司先后发布了更加快速、高效、精确的网织红细胞计数仪器,例如Abbott,Sysmex等公司。
从20世纪60年代起,国内开始兴起了细胞计数器的研发。1965年,国内首款血液细胞计数仪器诞生于上海。20世纪70年代,北京制造出了能进行简单细胞计数功能的仪器。这些早期仪器只具备RBC和WBC计数功能。后来,随着计算机技术的快速进步与算法的丰富,国内有的企业和外企进行合作,生产了一批性能优于第一代的细胞计数产品,此为第二代细胞计数产品, ERMA PC-603和PC-604型细胞计数仪器是第二代产品中性能最好,使用最广泛的。在过去的两三年里,中国的一些高科技产业投资了第三代血细胞分析仪的生产,该分析仪性能优越,能分析出细胞的18个重要参数,且具有细胞分类功能。至今,TECOM公司运用自动稀释技术生产出了TEK-2000仪器,它可以使用静脉或外周血,每小时能提取60个样本,使用方便,为国内自制血液分析仪开辟了良好的开端。
1.3 本文研究内容
本文设计的内容是对血液细胞图像进行分割和计数,将血液细胞图像中的细胞从图像背景中分割出来,对于重叠在一起的细胞采用图像分割技术将其分割成单个细胞,位于图像边缘的细胞也能准确的识别出来,并且在此基础上自动算出细胞的数目,细胞计数误差小于5%。
第2章 方案论证与设计
不同的血液细胞图像,细胞和背景颜色的对比度有差异,会存在颜色深浅,清晰模糊的不同,细胞重叠的严重状况存在差异,以及细胞位于图像边缘的特殊情况,要求血液细胞分割与计数系统对不同的血液细胞图像都能进行精准的分割和计数。所以图像分割是该系统能否计数精确的技术关键,目前常用的分割细胞图像方法有以下的三种[7],分别是边缘检测分割、阈值分割、区域分割,通过以下比较这三种细胞分割方案的优缺点,选取出最佳方案。
2.1 基于阈值的分割
阈值分割的基本原理是设置不同的阈值,把图像中的像素划分成几个范畴[8]。如果假设原图像为 ,根据某一特定的标准从中取得特征值,然后依据特征值把原图像进行分割,使其分为和两部分,经过分割之后,图像变为以下两部分:
如果取(黑色区域),(白色区域),这就是图像的二值化。
所以,可以看出,阈值的大小会决定图像二值化的效果。倘若选取了正确的的阈值,则可以精准的分割图像,但是阈值要是取的过高,那么就有可能把部分目标区域划分成背景,反过来,要是阈值取的过低,也会出现问题,系统会把部分背景当成目标区域进行划分。如果物体与背景的灰度值差别很大,待分割区域较清晰明显,那么运用阈值分割取得的效果会更好。否则,要是目标区域和背景之间的差异不是灰度值,而是其他特征,例如纹理的不同[9],可以将其不同的特征转成灰度值的特征差异,用阈值分割方法来分割图像。
阈值分割常用的一种分割方法是选择单个阈值,然后将图像上的所有像素与阈值进行比较,从而实现将图像进行划分,这种方法叫做全局阈值分割。但是该方法的局限是,如果同一张图像上不同区域的亮度不同,对比度存在较大差异,则可能会发生部分区域分割出错的问题。可以通过选取动态的阈值的方式来对不同的区域进行分割,根据不同的区分设置不同的阈值,这样可以改善单一阈值造成的分割差错,该方法叫做自适应阈值分割。阈值分割的方法有很多,应用范围很广。
2.2 基于边缘检测的分割
边界是物体的特征之一[10],物体的边界是一个图像中区别于其背景或其他物体的明显特征,其在对象和背景之间,对象和对象之间广泛存在。
边缘检测法的原理是,识别出不同物体的边界,并将其提取出来,从而实现图像分割,一般来说目标物体之间的边界上的像素,其灰度值会存在很明显的差异。一般位于图像的边界上,其周围的像素的灰度值的大小差别一般很大,因此梯度振幅大,物体内像素的灰度值大小的变化幅度较小 ,所以,可以通过计算一阶导数的的幅值,就能明确目标区域的边缘。计算得到二阶导数的符号,能明确该像素处于边界明暗中的哪一侧。不过,该方法还是会存在缺陷,噪声对其结果会产生不小的影响,如果目标区域的边缘像素的灰度值差异较小时,容易分割出错,边缘和背景发生混淆。
2.3 基于区域的分割
区域分割有两种典型的算法,分别是区域生长和区域分裂与合并[11],这当中区域生长是最经典的算法,区域生长的原理是先在图像中寻找某一个像素当作种子点,然后根据规则提取与种子点临近的像素,将其合并成新的种子点,再合并其临近的符合规则的像素点,以此类推,直到相邻像素不符合合并规则为止。该方法能将符合某特征的像素合并起来,从而实现分割图像。
以上是毕业论文大纲或资料介绍,该课题完整毕业论文、开题报告、任务书、程序设计、图纸设计等资料请添加微信获取,微信号:bysjorg。
相关图片展示: